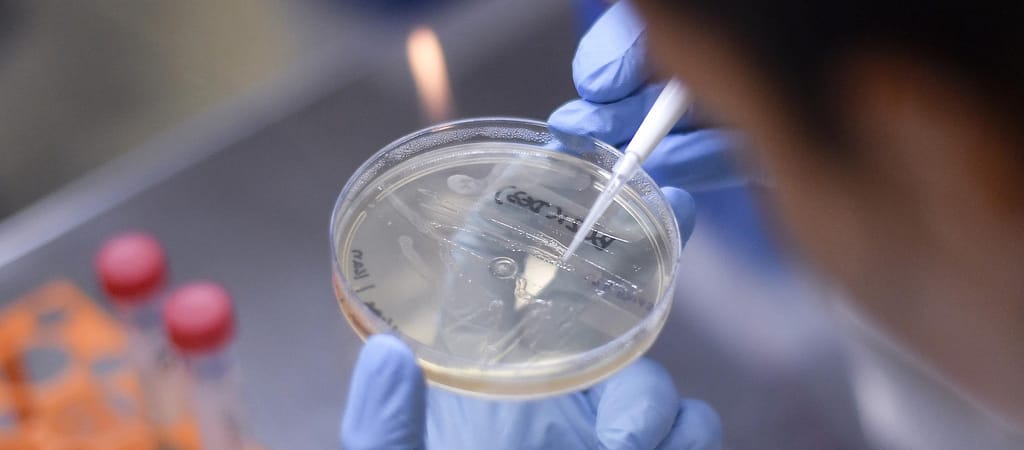

Két-három órán belül megvan a mintavétel eredménye, körülbelül hetvenezer forintba kerül.
Új szolgáltatást vezetett be a bécsi Schwechat repülőtér üzemeltetője: a repülőtérre érkező, vagy az onnan induló utasok telefonon és e-mailben akár előre foglalt időpontra is bejelentkezhetnek koronavírus-tesztre – írja az Airportal.
A vírus örökítőanyagát a szervezetben kimutató PCR-vizsgálatot a reptéren, helyben kialakított laboratóriumban végzik el, az eredményt két-három órán belül megkapja az utas.
A teszt költsége 190 euró (nagyjából hetvenezer forint).
Az osztrák szabályozás szerint azoknak az utasoknak nem kell 14 napos karanténba vonulniuk, akik négy napnál nem régebbi igazolással rendelkeznek arról, hogy nem fertőzöttek a COVID-19 betegséget okozó vírussal.
Ausztriába harmadik országok állampolgárai a schengeni övezeten kívülről nem léphetnek be, kivéve ha állandó tartózkodási engedéllyel rendelkeznek.
A repülőtéren minden utasnál testhőmérséklet mérést alkalmaznak, a terminálban mindenkinek az arcot és szájat eltakaró maszkot kell hordania, az utasok figyelmét a padlón elhelyezett jelölésekkel hívják fel a távolságtartásra, a csarnokokban kézfertőtlenítőket helyeztek ki, és a repülőgépek és a terminál között közlekedő buszokon is csak korlátozott számú utast szállítanak a földi kiszolgáló cégek. Az üzemeltető a check-in, a beszállító és információs pultoknál leheletfogó plexikkel védi a személyzetet.

 Ajándékozz éves hvg360 előfizetést!
Ajándékozz éves hvg360 előfizetést!